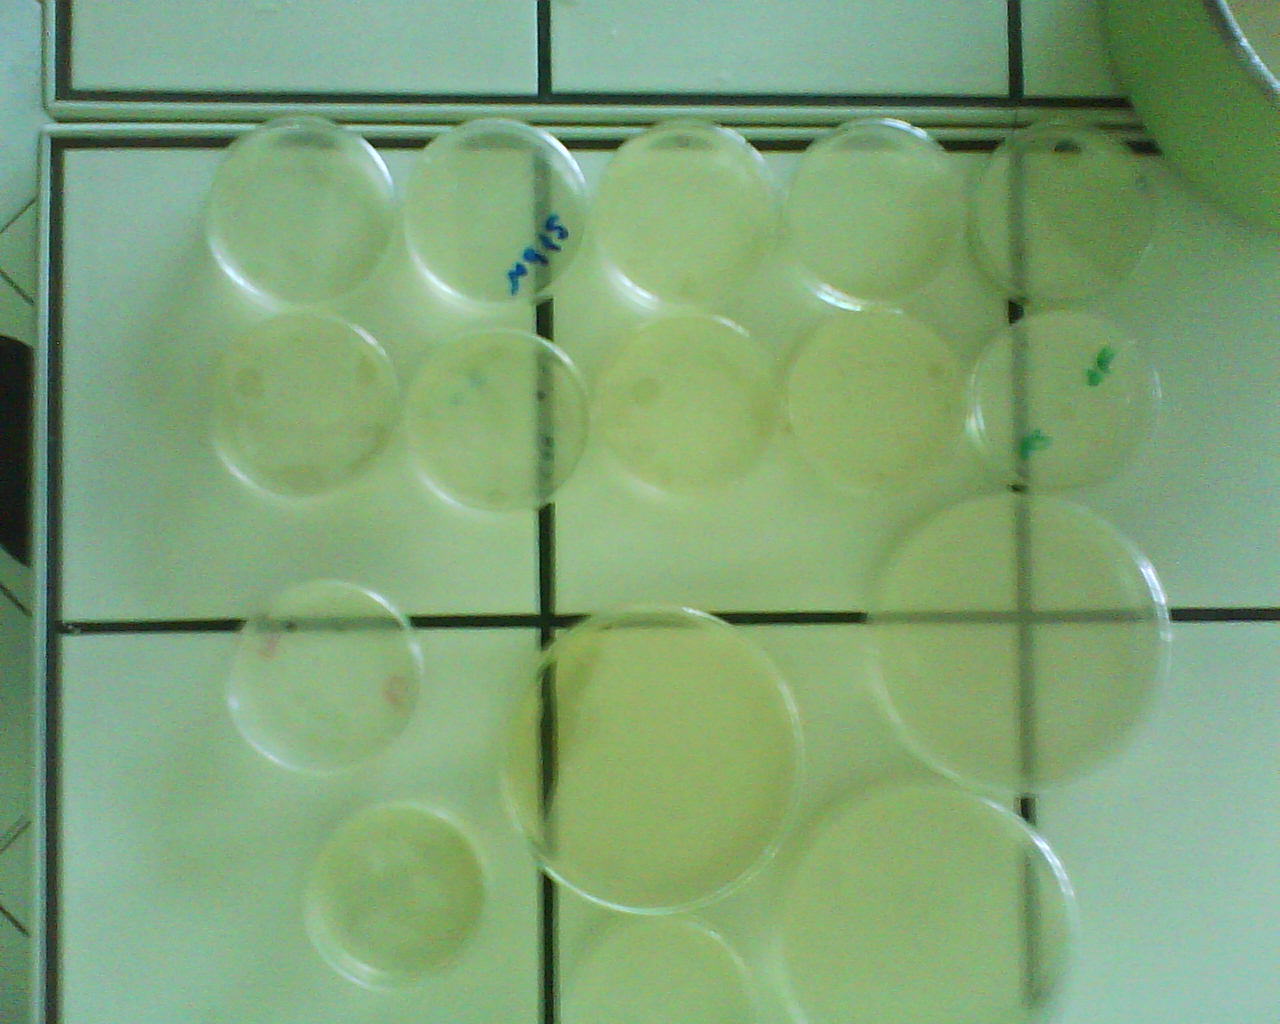
coupoles de g&eacute;l&eacute;tine

Enfin, on a réitteré l'expérience avec une température plus élevée pour prouver la présence d'enzymes en les dénaturant, c'est à dire en les "cassant" les liaisons peptidiques), c'est pourquoi aucunes dégrations n'a eu lieu.


-De plus, il faut savoir que nous avons effectuer les mêmes tests à chaud comme à froid et que leur tests s'averent négatifs par conséquent nos lessives ne contiennent pas d'enzymes.
Pour y remédier, on a inséré des enzymes. Vous n'aurez là aussi aucunes difficultés à effectuer cette tâche. Puisque d'après nos recherches, l'ananas a une capacité de dégradations enzymatiques assez impréssionnantes car c'est bien la solution qui a le plus dégradé nos gélatines.
CONCLUSION DE LA PREMIERE PARTIE :
Cette première partie a consisté à faire apparaitre la trace évidente d'enzyme dans les lessives de nos magasins et souligner le fait qu'elles sont responsables de la dégradation des tâches organiques ce qui par conséquent nous mène vers les tests de nos lessives naturelles pour garder une lessive réagissant avec les mêmes principes.
DEUXIEME PARTIE: TESTS ENZYMATIQUES SUR DES ECHANTILLONS DE NOS LESSIVES VEGETALES
- Sur ce second plan nous avons procédé de la même manière mais à partir de nos lessives , dont les secrets de la confection vous ont été dévoilé dans la rubrique : "matériels et protocoles ",
ainsi nous les avons testé en proportions égales et toujours sur la même matière organique : la gélatine .
RESULTATS: Sur l'ensemble de nos lessives biologiques, et bien aucunes ne dégradent la matière organique puisqu'il n'y a eut strictement aucunes dégradations sur les gélatines ( nous n'observons aucunes formations de trou sur la surface organique), ce qui veux dire que nos lessives ne contiennent aucunes enzymes et ne dégradent pas les tâches organiques. Et même résultat pour le test à chaud, ce qui est évident vu les résultats précédents. Mais aucun problème puisque nous pouvons introduire dans nos lessives des enzymes contenues dans du concentré d'ananas . Et ensuite , nous avons ensuite testé ces lessives , les tests étaient positifs , nos lessives étaient devenus des lessives dégradantes.